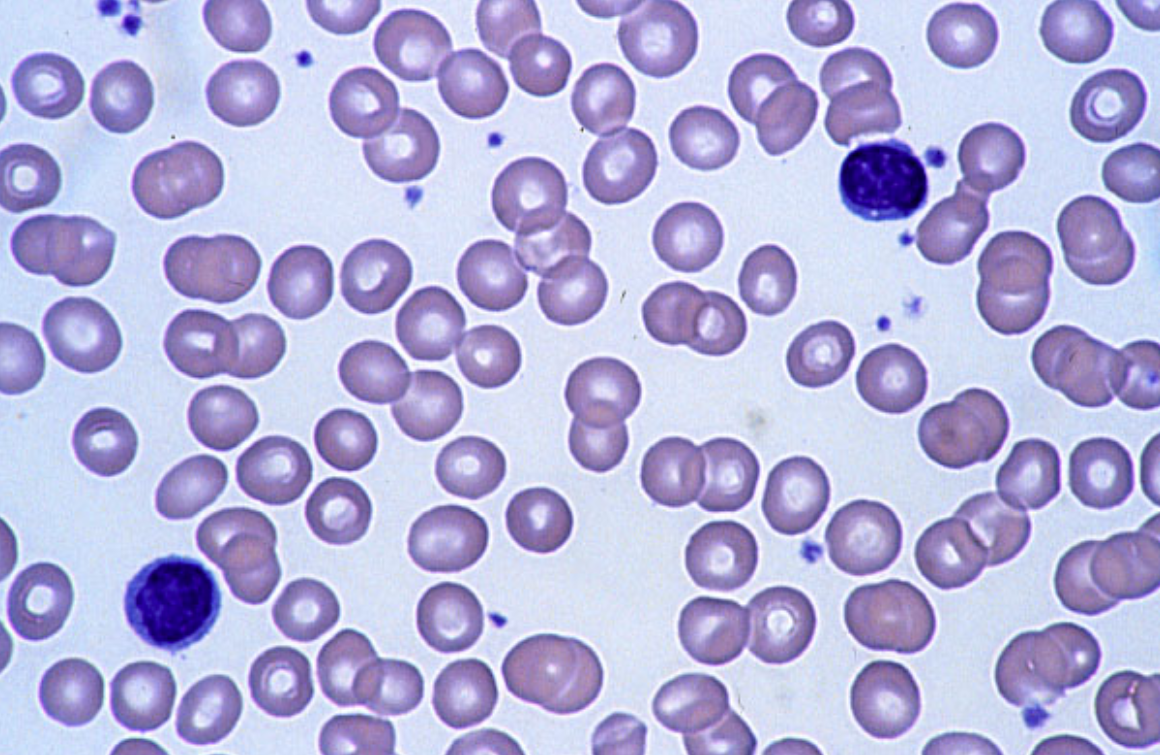
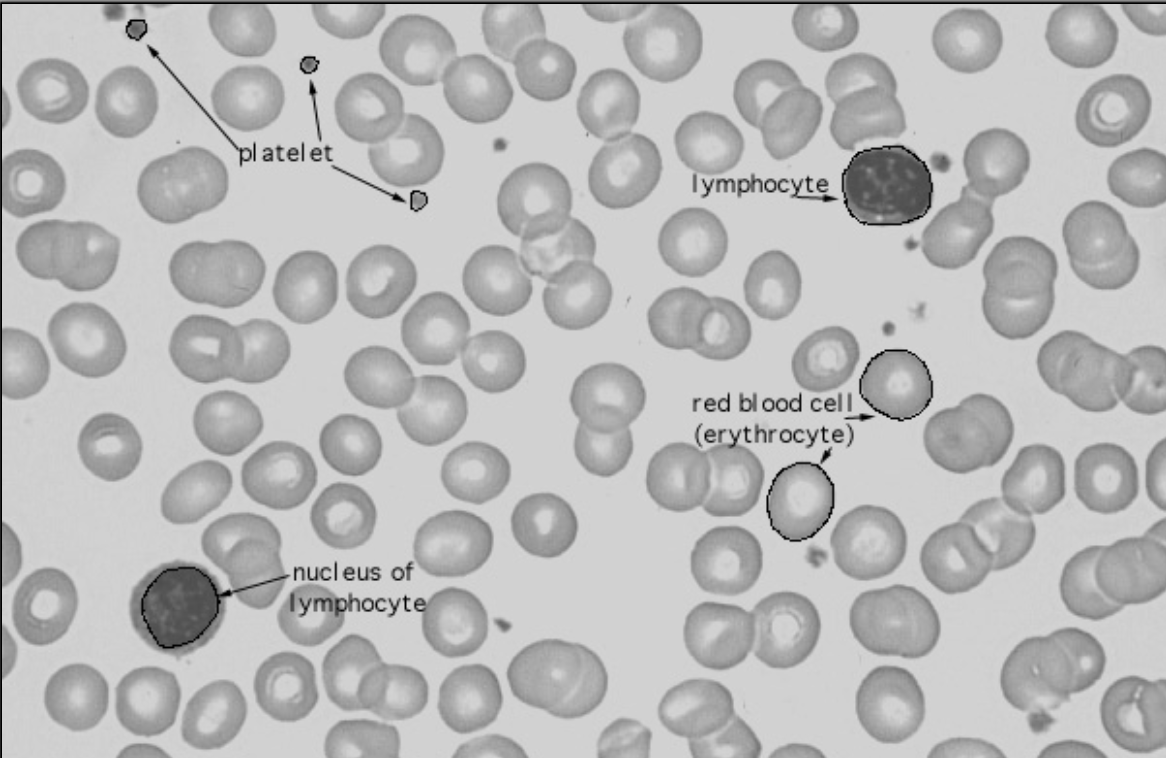
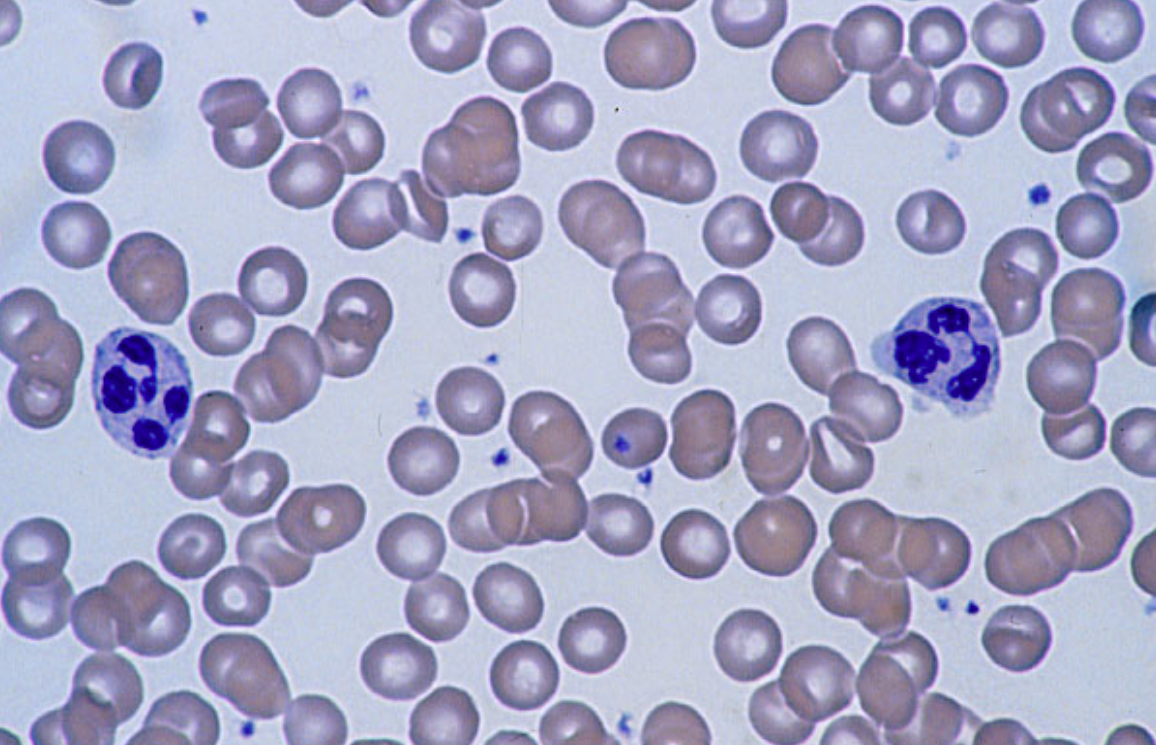
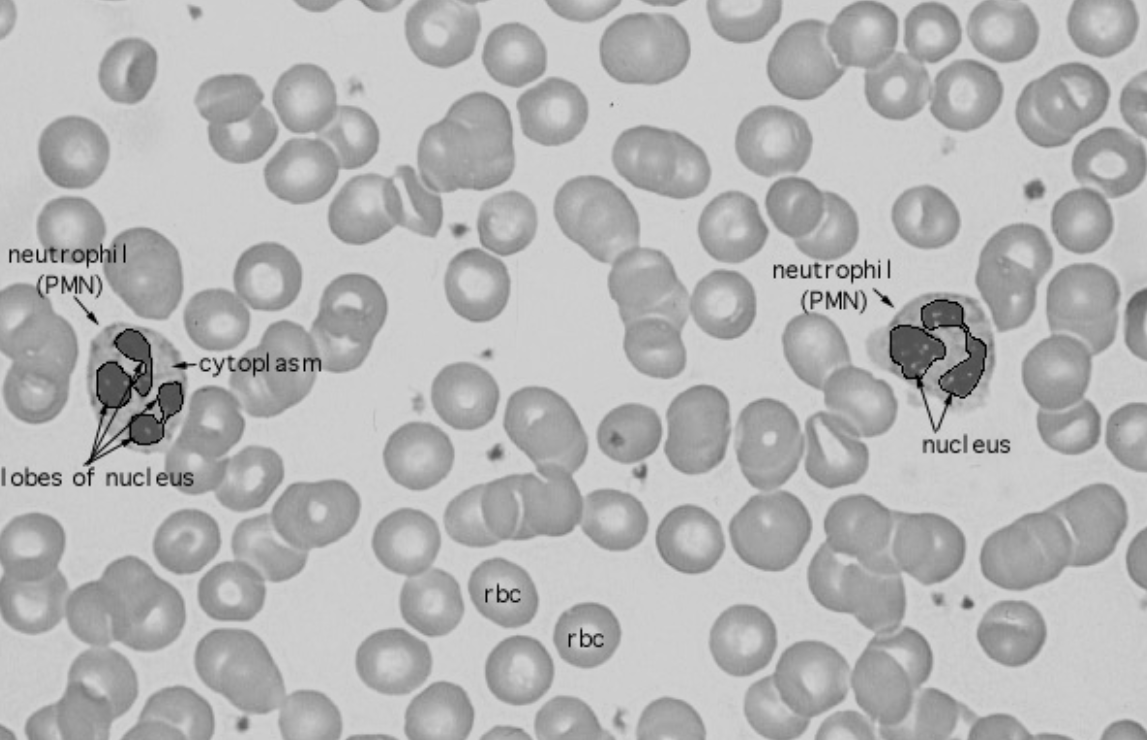
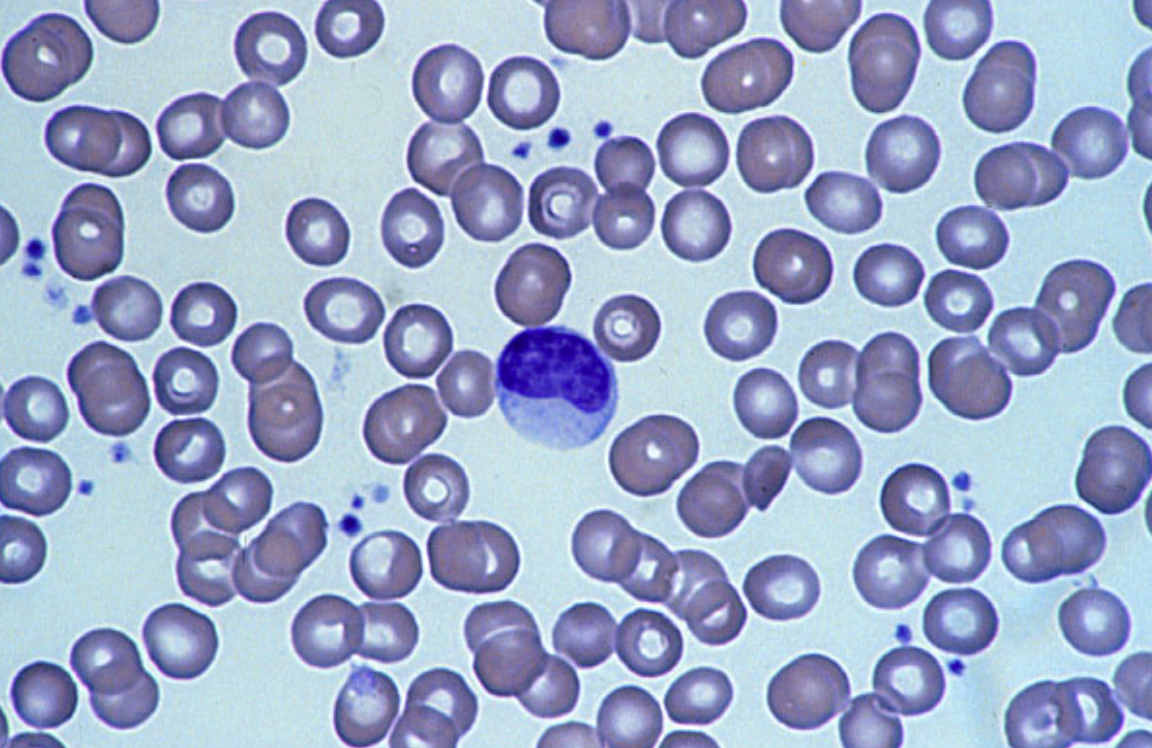
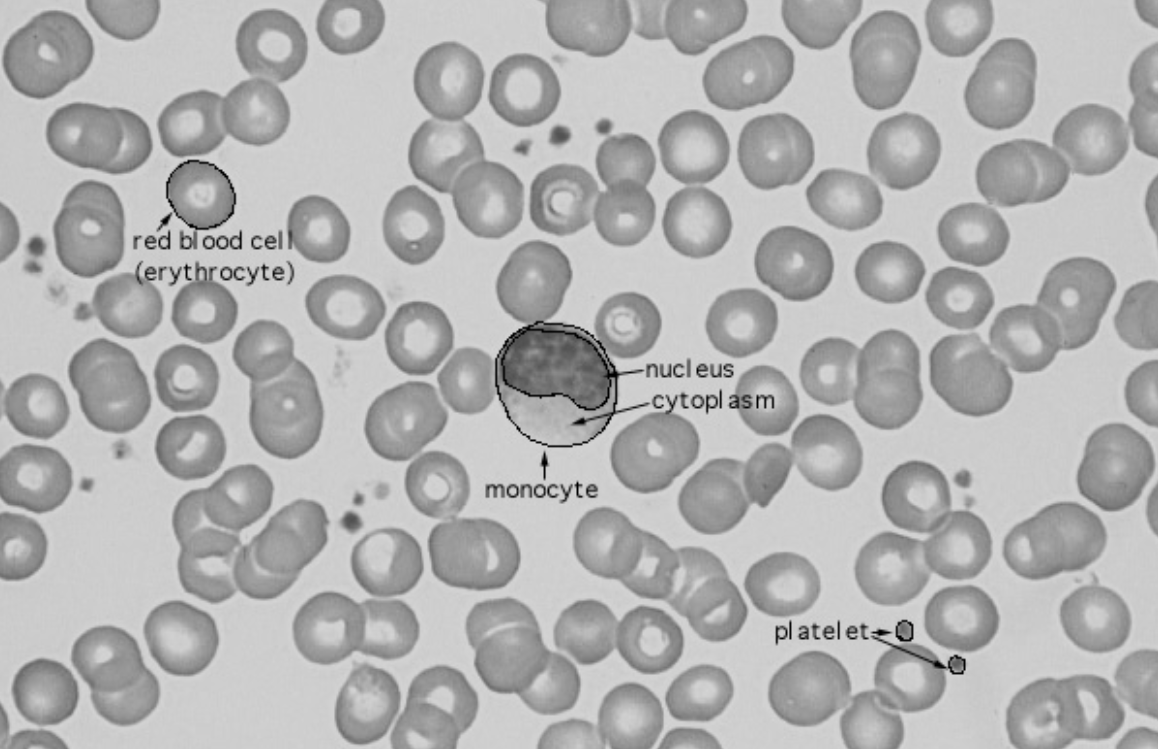
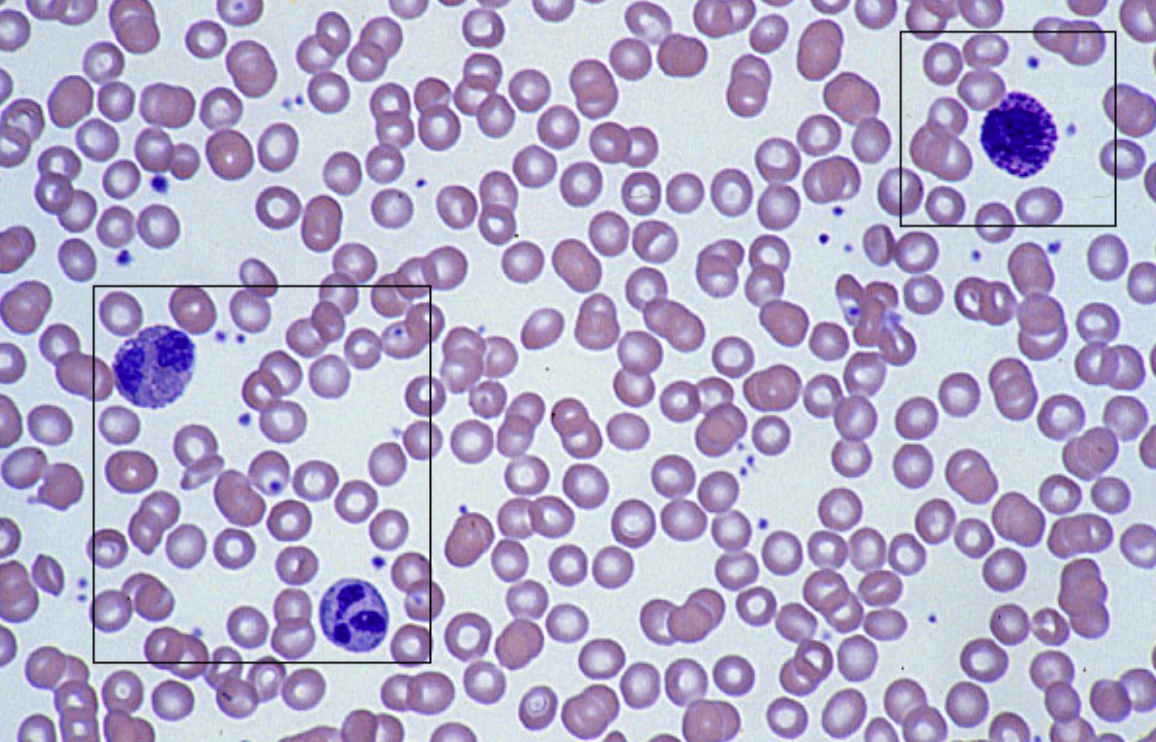
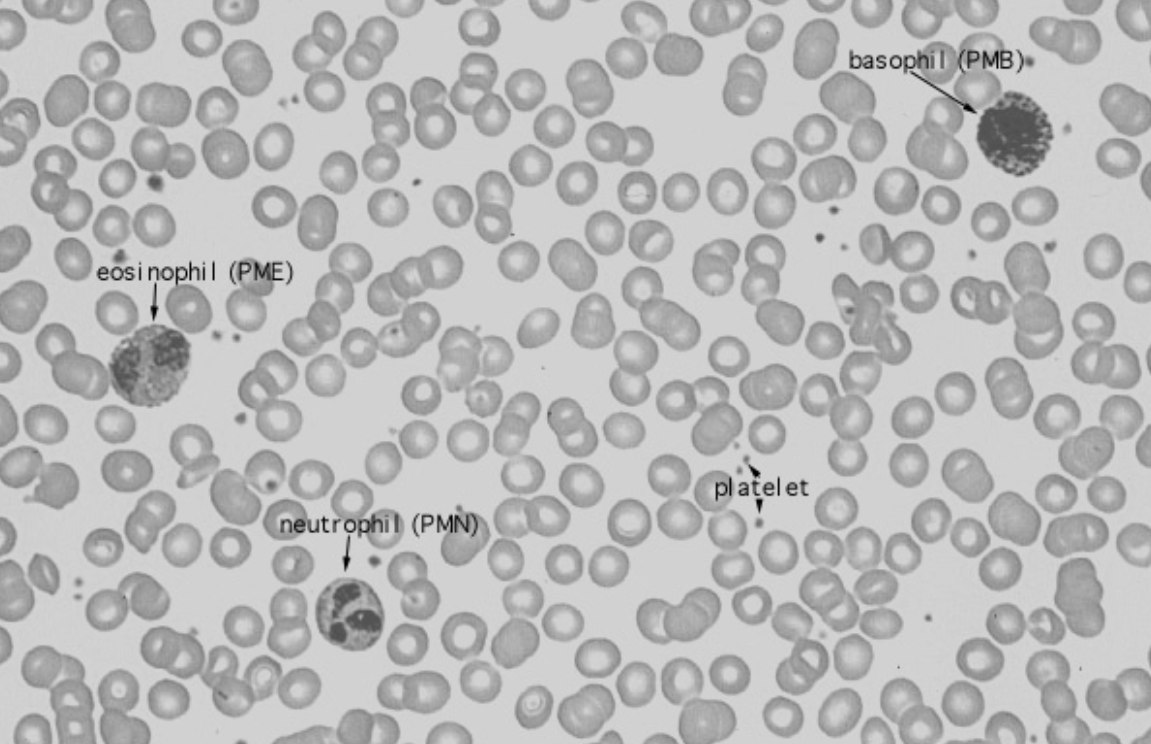
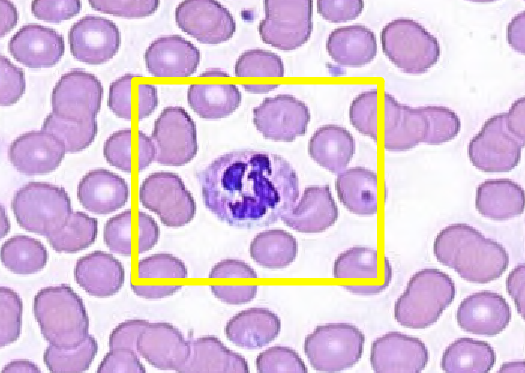
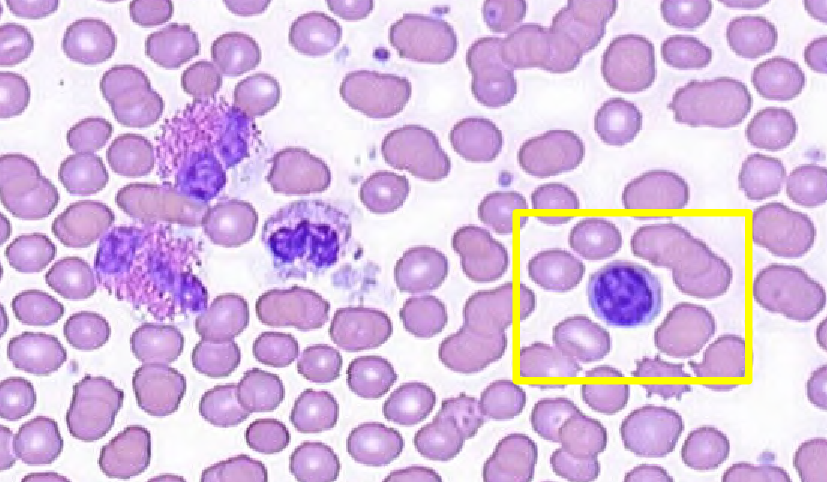

Name the cells here

Eosinophil granules contain major basic protein.
Name the layers and tissues here (GI)


Relative frequencies of leukocytes in blood
Never Let Monkeys Eat Bananas; neutrophils (60%), lymphocytes (25%), monocytes (10%), eosinophils (3%), basophils (1%)
Highlighted: neutrophil. Notice the unstained granules
Highlighted: lymphocyte. Notice contrast between eosinophils and neutrophil.

Stratified squamous non-keratinized epithelium
Types of epithelium tissues
Simple: squamous (endothelium, mesothelium), cuboidal, columnar
Stratified: squamous (keratinized, non-keratinized), cuboidal, columnar
Pseudostratified
Transitional/uterine
What’s the name of the transitory area here?

Pectinate line (transition between simple columnar and stratified squamous non-keratinized epithelium)
What type of epithelial tissue is this?

Stratified squamous keratinized tissue. Notice difference in nuclei between keratin and squamous layers.
What layer is this?

Serosa layer (mesothelium + connective tissue)
What is the general name for this layer? What are the specific names of the 3 GI layers shown?

General: mucosal layer
GI layers (inner to outer): epithelium, lamina propria, muscularis mucosae
Name the GI layers and their composition beyond the mucosa here.

Submucosa (CT), muscularis externa inner circular (longitudinal cut smooth muscle), muscularis externa outer longitudinal (transverse cut smooth muscle), serosa/adventitia (CT and mesothelium)
Types of tissues
Epithelium, connective, muscle, neuronal
What types of vessels are these?

Venules (notice color of smooth muscle vs color of vessel lining)
What are the 2 large vessels shown here?

Arteriole and lymphatic vessel above it. Notice color of arteriole lining vs. muscularis externa and irregularity of CT lining of lymphatic. Also notice lighter endothelium vs smooth muscle surrounding arteriole.
What are the large structures here?

Skeletal muscle. Notice size of fibers and darker color due to mitochondria.
What type of epithelium is shown here?

Simple columnar epithelium, cut longitudinally
What type of epithelium is shown here?

Simple columnar epithelium, cut is oblique or tangential
Which 2 cell types are present here?

Enterocytes and goblet cells (mucus is stained pink)
Which cell is this?

Plasma cell; clock nucleus, basophilic cytoplasm, Golgi exclusion
Which cell is this?

Lymphocyte







































































































